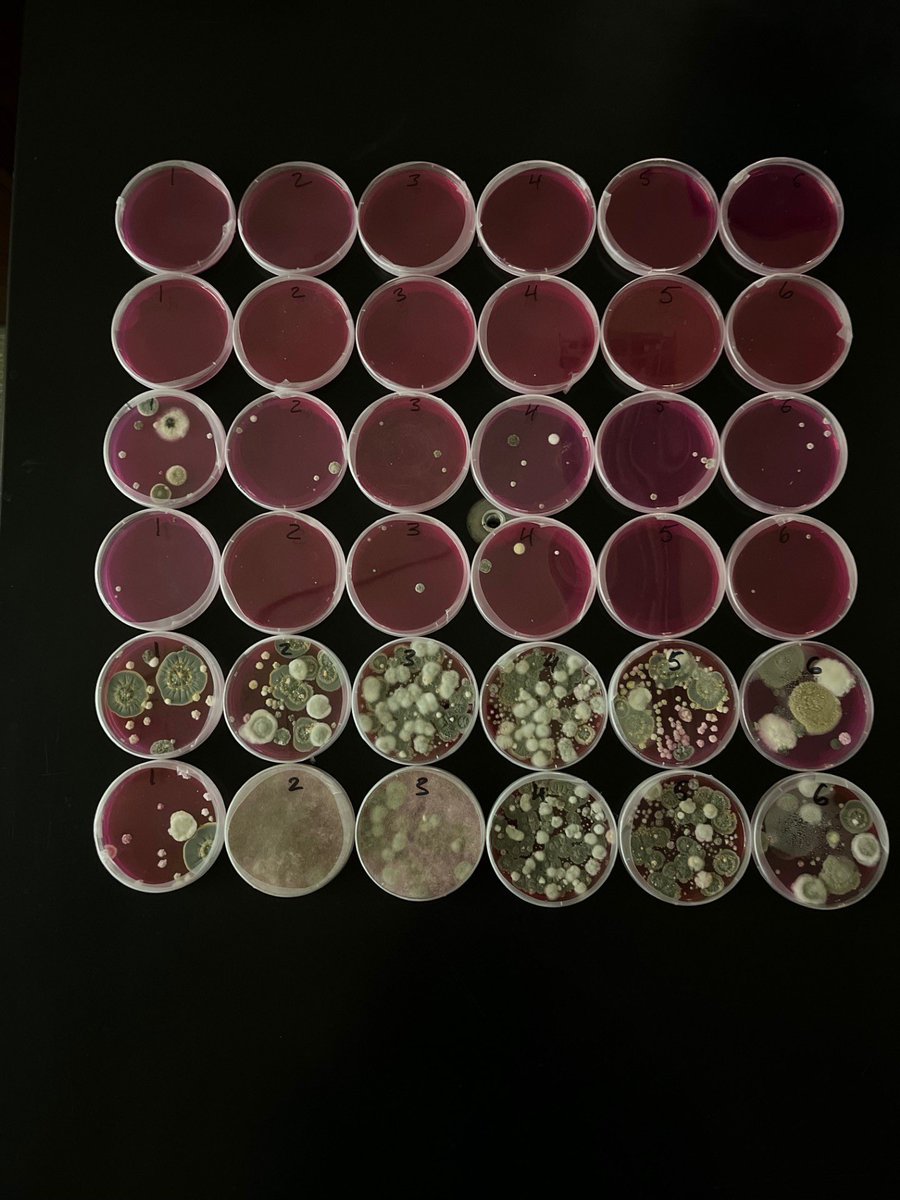

ScienceKS
@ksciencefest
Creating STEAM experiences that spark excitement and curiosity in learners of all ages. | April 27th, 2024. | Presenter signups are open now!
ID: 1481776126372503555
https://sciencefestks.org/signup/ 13-01-2022 23:53:29
186 Tweet
98 Followers
59 Following

🍎PHYSICS APPLIED EVERYWHERE! 🍎 Physics isn’t just for the classroom – it’s the fundamental force shaping everything around us! Find Dr. Ashif Akram and his team at the Manhattan Public Library on April 26th. Don’t miss out on this chance to see how physics impacts the world we live in!


✍️ POET IN THE BOX 📦 Did you know that the Kansas Science Festival isn’t just a STEM event, but a STEAM celebration? 🧪 🖼️ We are so excited to announce that the English Department is bringing back one of the crowd’s FAVORITE activities on April 26th at Manhattan Public Library!!!



💤🧑⚕️ANESTHESIA AND SURGERY Come visit their booth at Manhattan Public Library on April 26th, ask all your questions and learn about science of anesthesia and surgery!



@aandhfarm are back for Kansas Science Festival 2025! Always a crowd favorite, we can’t wait to host them on April 26th outside of the Manhattan Public Library Follow them on social media for updates and events! Facebook: facebook.com/AandHFarm TikTok: @aandhfarm Instagram: @aandhfarm



Find Chapman Center for Rural Studies at @manhattanpublib on April 26th to see your name come to life through a spectrogram, a tool that transforms sound waves into stunning visual patterns!



Fungal Ecology group will demonstrate how fungi can grow in building materials and will provide an opportunity to see these fungi under a microscope. Find them at the Manhattan Public Library on April 26th and get close-up view of mycelium and spores through a microscope!

Find K-State Cancer Research booth at the Manhattan Public Library on April 26th to learn more about how they study cancer and the steps they’re taking to fight it.


Find Popenoe Entomology Club booth at Kansas Science Festival at Manhattan Public Library on April 26th to explore the wonders of the insect world!


The KSU Kansas Radon Program sosradon.org is a non-profit that serves Kansas communities and individuals through free radon education, outreach, and technical assistance. Find their booth on April 26th at Manhattan Public Library and learn about how radon can affect your home and health!


Find their booth at Manhattan Public Library on April 26th to learn more about the latest innovations in plant and animal health that help us provide safe and nutritious food to communities everywhere.


Their mission to make gaming fun and accessible for everyone! Find “Accessible games” booth at Manhattan Public Library on April 26th as they play-test games for accessibility and modify them so no one gets left out of the action.


🥬THE VEGGIEMETER 🥬🥦 We’re excited to host The Veggiemeter at this year’s Kansas Science Festival, presented by K-State nutrition professors! Find their booth at Manhattan Public Library on April 26th to learn the amazing benefits of colorful, nutrient-packed foods for your health!


We are proud to announce Security Benefit as a Block sponsor for 2025 Kansas Science Festival! 🤗🥳 It is not too late to sponsor the upcoming festival 🎉 Visit our website sciencefestks.org or follow the PayPal link in the page caption to make donation









